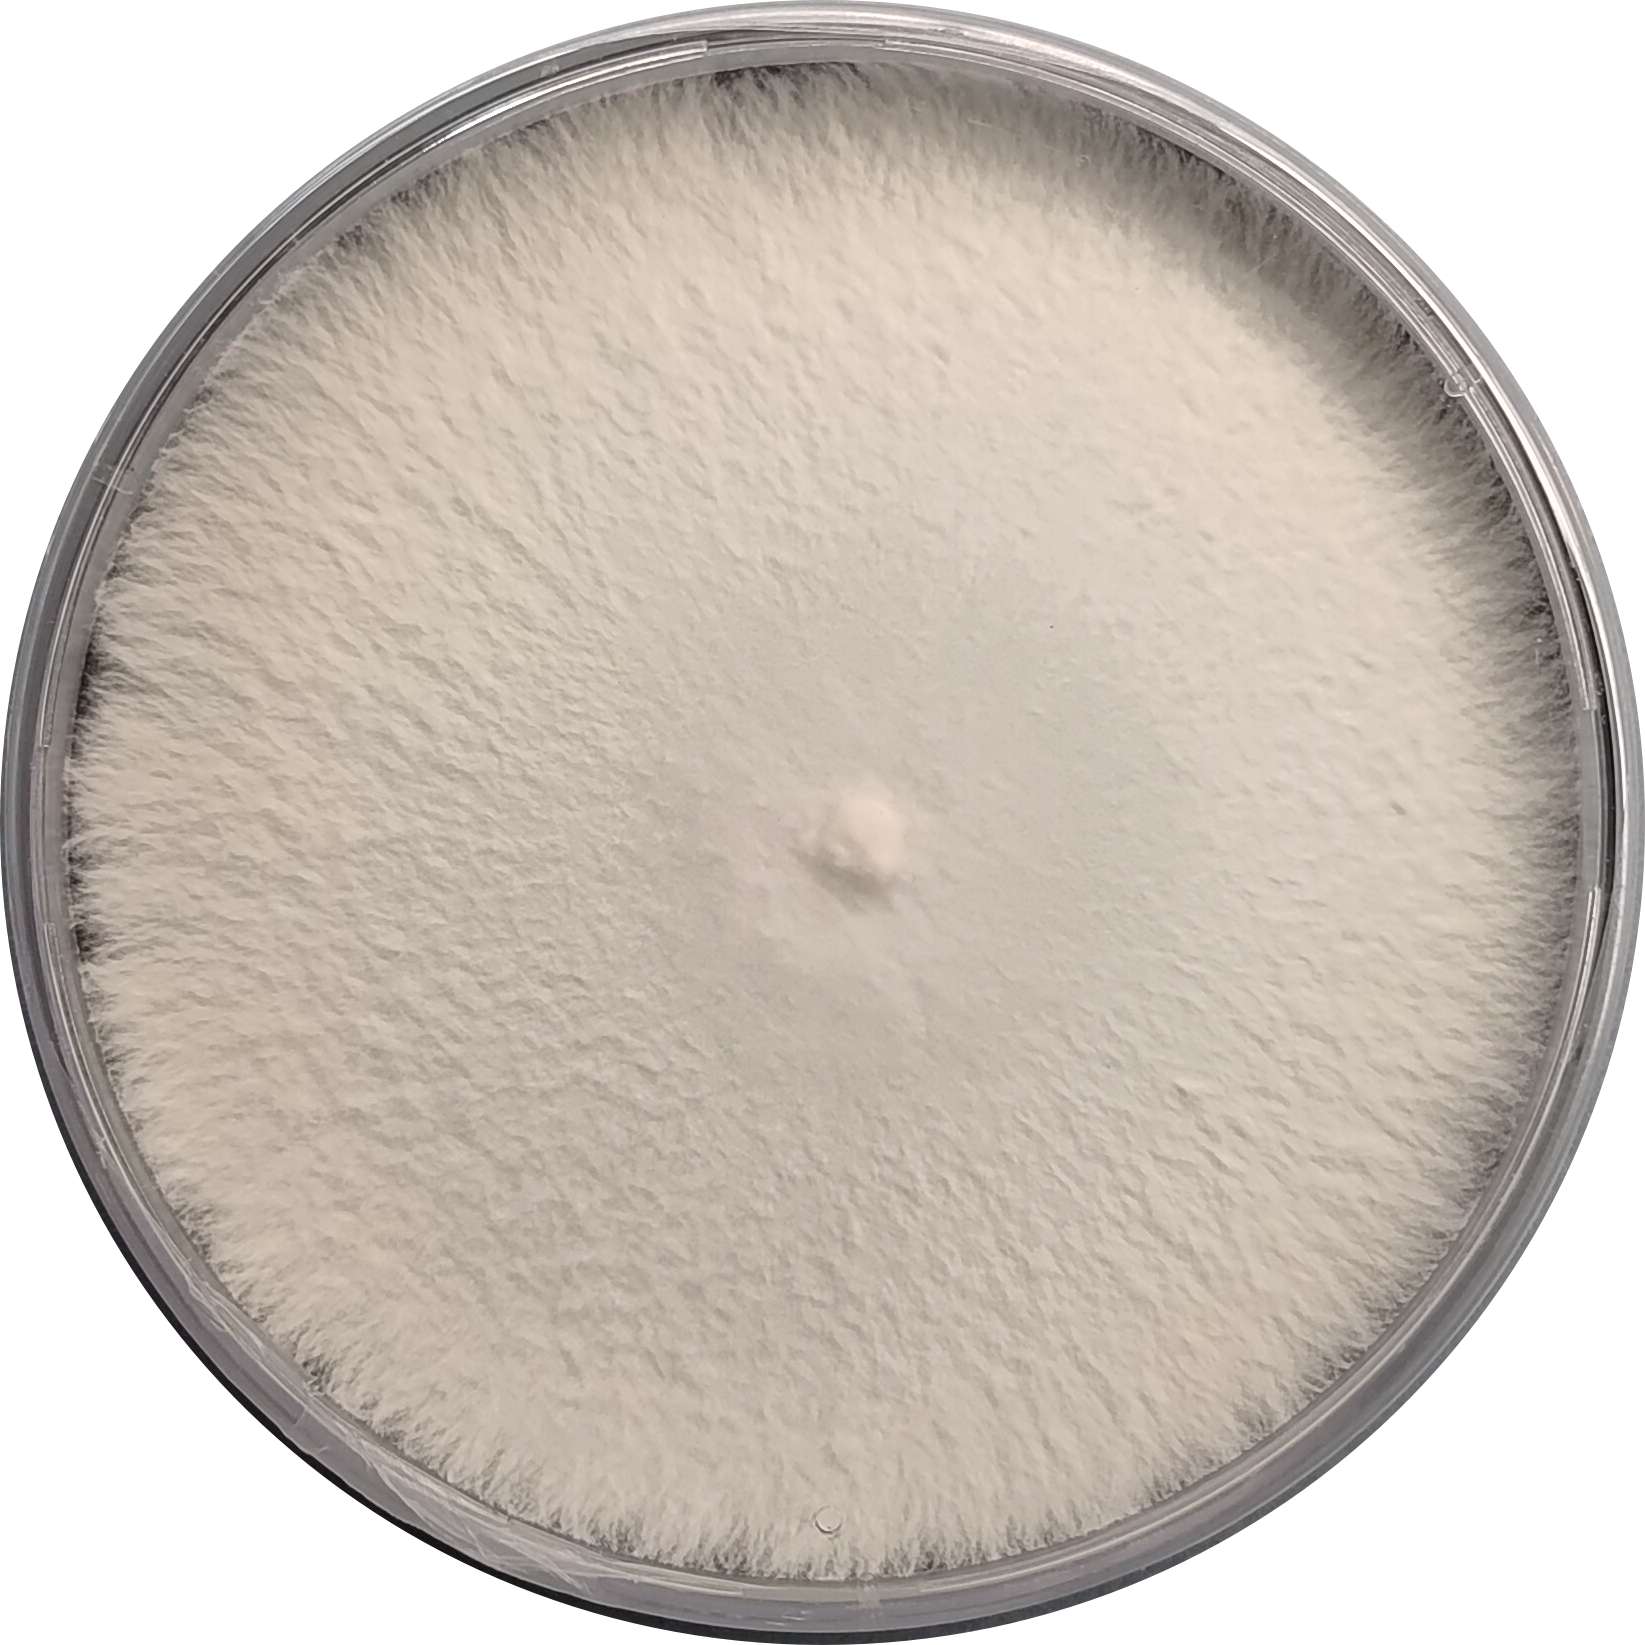
Ganoderma formosanum Black Reishi Culture

Tremella fuciformis Snow Fungus Culture
₹2,500.00
Out of stock
This product is currently sold out.
No worries! Enter your email, and we'll let you know as soon as it's back in stock.
Unlock the therapeutic and culinary wonders of Tremella fuciformis (Snow Fungus) – Agar Culture Plate , known popularly as Snow Fungus or White Jelly Mushroom. Cultivated meticulously at Agripie’s advanced labs, this pure culture plate provides robust and contamination-free mycelium ideal for mushroom enthusiasts, hobbyists, and commercial cultivators.
Celebrated for its rich nutritional profile and revered in traditional Chinese medicine for centuries, Snow Fungus is an excellent immune booster, skin enhancer, and culinary delicacy. Easy to cultivate, Tremella fuciformis produces distinctive translucent, gelatinous fruiting bodies valued for their health-enhancing polysaccharides and anti-aging properties.
Specifications:
-
Species: Tremella fuciformis
-
Format: Pure culture plate
-
Storage: Can be stored at 4-8°C for 3 months until use.
-
Viability: Guaranteed fresh and viable culture
Cultivation Tips:
-
Maintain temperatures between 20-24°C for optimal growth.
-
Ideal substrate includes hardwood sawdust, rice bran, or supplemented wood chips.
-
Ensure sterile technique when transferring to substrate for best outcomes.
Why Choose Agripie’s Cultures ?
-
✅ Pure, Healthy Mycelium: Ensured contamination-free for high-quality results – multistrata quality checks passed !!!
-
✅ Ideal For: Perfect for beginners and commercial cultivators, Academics and Research, Industrial applications, etc.
-
✅ Culture Formats: Cultures available in Agar Plate, Syringe, Long-term storage Format – choose as you need.
-
✅ Antibiotic-free Media: All our culture formats are prepared on antibiotic-free media.
-
✅ Proudly Made in India 🇮🇳: Grown and tested in Agripie’s premium facility.
| Weight | 0.1 g |
|---|
Only logged in customers who have purchased this product may leave a review.

Reviews
There are no reviews yet.